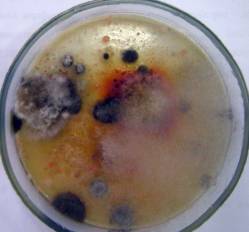
C:\Users\�����\Desktop\1.jpg
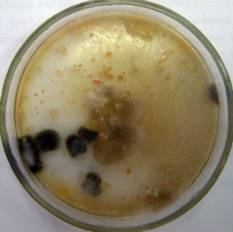
C:\Users\�����\Desktop\3.jpg

Короленко
А.В., Устимчук Ю.П., Тетеріна С.М.
Національний
університет харчових технологій, Україна
Аналіз мікрофлори соку цукрового
сорго
Вступ
Зміна клімату в Україні значною мірою
повторює динаміку глобальних кліматичних змін: у таких умовах збільшується
кількість несприятливих погодних умов, зокрема пов’язаних з високими
температурними показниками. Збільшується частота посушливості на території
України загалом. Взагалі посухи властиві клімату України, однак останніми
роками вони почастішали, охоплюючи раз на 10–12 років до 50–70% території
країни [1]. Спостерігається тенденція їх поширення на регіони, які донині
вважалися зонами достатнього зволоження – північні та західні області, що
призводить до зменшення кількості врожаю сільськогосподарських культур, а отже
і сировини для багатьох галузей промисловості. Дані події вимагають збільшення
кількості вирощування посухостійких культур.
Перспективною
сировиною для отримання цукровмісних харчових продуктів та різних видів
біопалива є цукрове сорго, яке дає високі і стабільні врожаї зерна та зеленої
маси навіть в жорстких кліматичних умовах. Важливим є те, що сорго за посухо-
та солестійкістю займає перше місце серед сільськогосподарських культур у світі
[2].
Цукрове сорго є
альтернативною сировиною для отримання харчового сиропу, оскільки у соку стебел
цукрового сорго міститься 14…20% вуглеводів, а також амінокислоти, макро- та
мікроелементи. Сироп набув широкого розповсюдження в харчовій галузі в якості
сировини для отримання алкогольних та безалкогольних напоїв, які можуть
виготовлятися як безпосередньо лише з соку, так і з додаванням інших фруктових
соків (наприклад сквош), фруктових та білкових концентратів [3].
Однак, при
виробництві будь-яких харчових продуктів постає питання забезпечення їх високої
якості та безпеки. Одним з чи не найважливіших показників безпеки є
відповідність харчового продукту мікробіологічним показникам.
Метою даних
досліджень було визначення мікробіологічних показників соку цукрового сорго
сорту нектарний який культивується в Україні та може бути запропонований в
якості похідної сировини для виробництва слабоалкогольних та безалкогольних
напоїв.
Матеріали і методи
В ході аналізу
використовували методи прямого та непрямого мікробіологічного аналізу.
Для проведення
прямого аналізу морфологічних ознак виділених з соку цукрового сорго культур
мікроорганізмів здійснювали мікроскопіювання препаратів «роздавлена крапля»,
підфарбовуючи їх метиленовим синім для кращого контрасту, а також
використовували метод Буррі-Гінса для виявлення капсул.
При проведенні
непрямого аналізу використовували метод Коха. В якості поживних використовували
наступні середовища: м'ясо-пептонний агар (для визначення загального мікробного
числа), середовище Сабуро (для виділення грибів та дріжджів), середовище МРС (для
виявлення молочнокислих бактерій), а також середовища Кеслера та ЕНДО (для
виявлення бактерій групи кишкової палички).
В ході
досліджень було проаналізовано проби сирого соку сорго, одержаного шляхом
пресування попередньо подрібнених стебел цукрового сорго різних врожаїв
зібраного за різних погодних умов та отриманого традиційним пресовим с
способом. Також було проаналізовано
змиви з технологічного обладнання, виконані до миття пресу, після його миття
водопровідною водою, а також після оброблення пресу антимікробним засобом на
основі природних β-хмелевих кислот «Бетастаб».
Результати
Проаналізувавши
морофолого-культуральні ознаки культур, виділених з соку цукрового сорго різних
врожаїв, та провівши кількісний підрахунок колонієутворюючих одиниць (КУО) на
чашках Петрі, було виявлено значну відмінність як в якісному (Рис.1, Рис.2),
так і в кількісному складі мікрофлори зразків. Так вміст мікроорганізмів у
пробах сирого соку становив: від 3·105 КУО до 2,5·106.
Дана різниця може пояснюватись відмінністю погодних умов вирощування
(температура повітря, наявність опадів), способів та термінів збирання врожаю,
тривалості та умов зберігання рослин з моменту їх збору до переробки. Так,
серед культур, в різних кількостях, були виявлені бактерії родів Bacillus та Enterobacter, а також дріжджі родів Rhodotorula і Saccharomyces.
Серед домінуючої мікрофлори виявлені молочнокислі бактерії родів Lactobacillus, Lactococcus та Streptococcus,
а також слизоутворюючі бактерії роду Leuconostoc.

Рис.1 Рис.2
Мікрофлора
соків цукрового сорго врожаю 2012 року
Значну роль з
точки зору виготовлення безпечної та якісної харчової продукції, відіграє
належна санітарно-гігієнічна підготовка, тому актуальним було проведення
мікробіологічного аналізу ефективності використання дезінфікуючого засобу на
основі природних β-хмелевих кислот для санітарної підготовки процесового
обладнання перед отриманням соку зі стебел цукрового сорго.
В результаті
проведених досліджень соку цукрового сорго та змивів з обладнання виявлено
велику кількість аеробних бактерій та дріжджів, джерелом яких могли бути, крім
власної мікрофлори рослин, ґрунт та вода. Зокрема, аналіз вихідного змиву з
пресу показав, що на його поверхні містилось 2,1·103 КУО/см2,
після миття водопровідною водою кількість мікроорганізмів зменшилась і складала
2,6·102 КУО/см2, а після оброблення робочим розчином
антимікробного засобу на поверхні пресу залишилось 1,6·102 КУО/см2.
Відповідно соки отримані на даному обладнанні мали наступні мікробіологічні
показники: до миття пресу – 7,4·105 КУО/см3, після
миття пресу – 4,2·105 КУО/см3, а після оброблення
антимікробним засобом – 2,3·105 КУО/см3.
Результати
досліджень свідчать про ефективність використання антимікробного засобу
«Бетастаб», щодо зниження мікробного обсемінення поверхонь обладнання, а також
підтверджують вплив наявності мікробного забруднення робочих поверхонь пресу на
рівень мікробного обнасінення одержаного соку.
Отже, в
результаті проведених досліджень можна зробити висновок про необхідність
попередньої підготовки обладнання перед одержанням соку із стебел сорго із
застосуванням антимікробних засобів, оскільки наявна на поверхнях мікрофлора
сприяє мікробному забрудненню отриманого соку і може негативно вплинути на
процес його подальшої переробки.
Література:
1. О. Фурдичко Як оминути бурі та посухи і подолати голод на планеті. – Віче. - № 1. – 2012. – С.15–17.
2. Григоренко Н.О. Цукрове сорго – перспективна сировина для цукрової промисловості / Н.О. Григоренко, А.Н. Савич // Наукові праці Одеської національної академії харчових технологій Міністерства освіти і науки України. – Одеса: 2006. – Вип. 28. – Т 2. – С. 363-364.
3. Datta Mazumdar, S and Poshadri, A and Srinivasa Rao, P and Ravinder Reddy, C. H. and Reddy. Innovative use of Sweet sorghum juice in the beverage // International Food Research Journal. – 2012. – V. 19. – № 4. – P. 1361-1366.